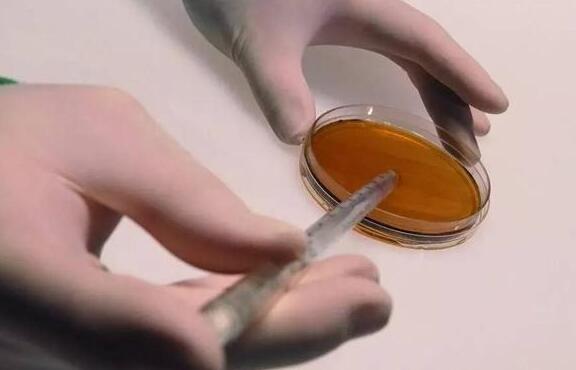
尿素销售前景怎么样,尿素为什么越来越便宜

产能过剩、竞争激烈、连年亏损、价格透明、市场低迷、利润微薄……
这几个关键词正成为大化肥厂家和经销商心头的之痛。尤其在去年农业部发布“化肥使用量零增长”计划之后,大化肥厂家和经销商靠继续增量来寻求发展的路子几乎被完全堵死。
然而就在此时,爱尔兰亚特兰蒂斯、意大利瓦拉格罗、意大利比奥齐姆、美国世科姆、法国缔马等等一大批欧美农资企业却携“减肥增效、减量提质”利器产品疯狂抢滩中国,这多少让国内农资企业颇感意外。仔细探查,我们发现这类产品都与一个神秘物质密切相关——生物刺激素。
其实,国内传统化肥企业也在加速转型升级,“零增长”下,靠“老产品”来实现企业增长已经穷途末路。传统化肥企业转型创新靠什么?一些企业已经在悄悄布局蓝海:
行业大鳄金正大集团,今年5月推出一款增效化肥——生物能尿素,并提出到2020年,发展增效尿素1000万吨,提高传统氮肥利用率10个百分点。据介绍,该款产品在传统化肥尿素的基础上特别添加了腐植酸、聚天门冬氨酸、锌、硼等微量元素以及其他独有生物能元素并利用螯合技术生产。据悉,已有的实验数据证实了该款产品的实力,该产品一经推出就受农资厂商的重点关注。
金正大不是大企业布局农资蓝海的孤例。化工百强企业昊华骏化集团,此前也推出锌腐酸复合肥。据称,该产品的核心技术是锌腐酸,一种天然肥料增效剂。该款产品,也同样是传统化肥产品与增效产品的创新结合。

北京澳佳生态农业股份有限公司,可谓是把腐植酸在肥料中的应用发挥得淋漓尽致。其核心技术就是“腐植酸+”,充分发挥腐植酸改土增效、水肥协调、提质抗逆的作用,通过先进的合成技术将腐植酸与传统肥料产品融为一体,不断挖掘腐植酸在农业生产应用中的潜力。
……
这类案例很多。在添加各类腐植酸之外,添加海藻酸、甲壳素、氨基酸和微生物菌剂的传统化肥厂家也在纷纷涌现,并快速抢滩提质增效类农资产品蓝海。
氨基酸、腐植酸、海藻酸、甲壳素、微生物菌,这些提质增效的宠儿们,正悄然被农资行业所认可,也被赋予了新的使命。多年来,农资行业对他们没有合理的认识,他们不是肥料,也不是农药,但微量使用后却可以有效减少化肥和农药的使用。这就是:生物刺激素。
然而由于作用机理不明确,相关科学研究滞后,生物刺激素并未被大多数企业所熟识,国内对这类产品也没有清晰的登记管理。这也使得生物刺激素被一些企业所忽略,甚至并不认可其发挥的神奇作用。
时至今日,生物刺激素已不再是农资企业的小众产品,已经加入传统化肥企业勇闯市场蓝海的秘密*器武**。传统企业该如何拥抱生物刺激素,生物刺激素如何与传统肥料产品完美结合,神秘与传统究竟能够碰撞出怎样的火花?
7月7日,中国生物刺激素峰会,让我们读透这个蓝海产业。
······················································
2016中国生物刺激素峰会
时间:7月7日·中国北京·香山饭店
主办:《农资导报》
协办:新田龙特种肥、广东神宝农业
联合协办:山东创新腐植酸科技股份有限公司
技术支持:中国植物营养与肥料学会施肥技术专业委员会
会议4大核心内容:
一、把脉政策走向
●中国生物刺激素登记管理走向
●生物刺激素类产品的中国标准探讨
●美国生物刺激素产业现状及管理
●欧盟生物刺激素市场及政策
二、剖析增效机理
●生物刺激素分类及作用机理
●微生物菌的分类、作用机理
●腐植酸分类、机理、农用效果
●海藻酸、甲壳素分类、机理、农用效果
……
三、产品实战路演
●矿源or生化:细数黄腐酸的秘密
●氨基酸与多功能水溶肥的组合效应
●中国市场需要怎样的微生物菌肥
海藻酸:十年冲锋 风口到没?
……
四、中外商机碰撞
●欧美正火的生物刺激素产品有哪些?
●中国需要怎样的生物刺激素产品?
●大化肥如何牵手生物刺激素?
参会咨询,点击下方图片链接即可!